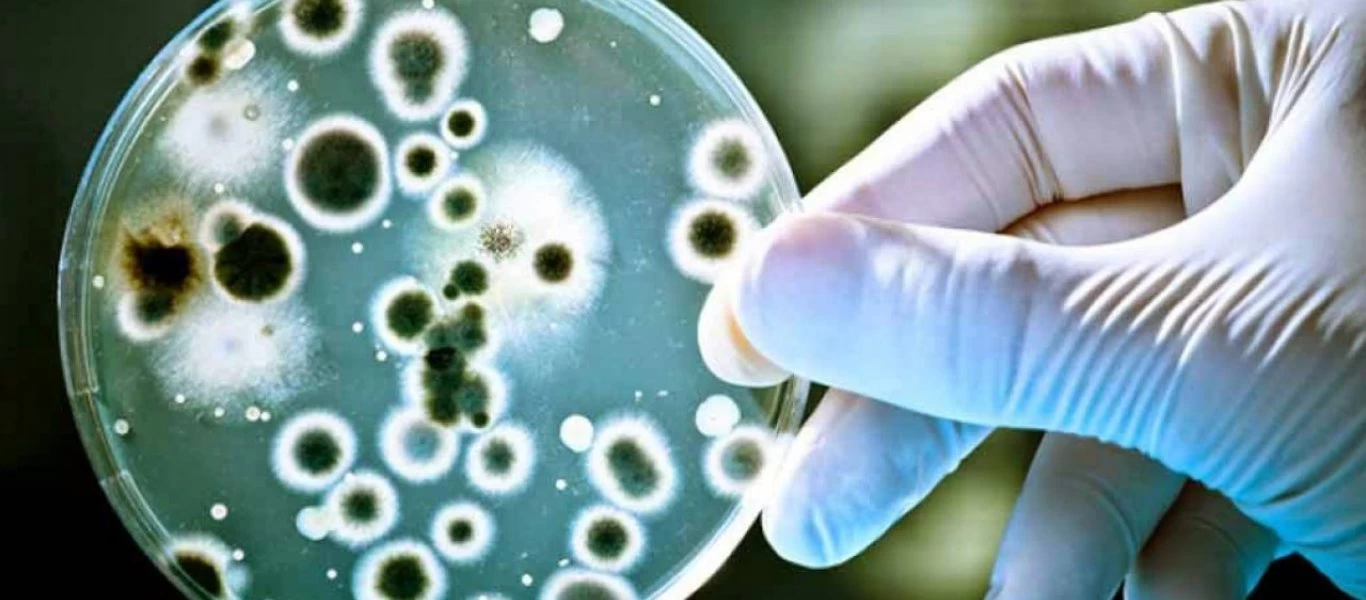
Τοξικές μυκητιάσεις: Ο άγνωστος κίνδυνος μέσα στο σπίτι - Τι έδειξε έρευνα

ΥΓΕΙΑ
-
Τοξικές μυκητιάσεις: Ο άγνωστος κίνδυνος μέσα στο σπίτι - Τι έδειξε έρευνα
Σύμφωνα με μια επιστημονική μελέτη, υπάρχουν αρκετές τοξίνες από μύκητες που θα μπορούσαν να απελευθερωθούν στον αέρα σε εσωτερικούς χώρους και η πηγή θα μπορούσε να είναι μύκητες που ζουν και αναπτύσ...
Read More » -

Αυτά είναι τα υπερτρόφιμα που μειώνουν κατά 33% τον κίνδυνο καρκίνου του πνεύμονα
Μια διατροφή πλούσια σε φυτικές ίνες και γιαούρτι σχετίζεται με μειωμένο κίνδυνο καρκίνου του πνεύμονα σύμφωνα με έρευνα του Ιατρικού Κέντρου του Πανεπιστημίου Vanderbilt που δημοσιεύθηκε στην JAMA On...
Read More » -

Ποιοι άνδρες κινδυνεύουν από καρκίνο του προστάτη;
Οι άνδρες που έχουν στο αίμα τους αυξημένα επίπεδα δύο ορμονών, της ελεύθερης τεστοστερόνης και του ινσουλινομιμητικού αυξητικού παράγοντα Ι (IGF-I), είναι πιθανότερο να διαγνωσθούν με καρκίνο του προ...
Read More » -

Η καθημερινή συνήθεια που πρέπει να ελέγχουμε
Τα τελευταία χρόνια είναι αναρίθμητες μελέτες που έχουν υποδείξει τους συσχετισμούς που υπάρχουν ανάμεσα στην κατανάλωση καφέ και στον περιορισμό κάθε είδους κινδύνου για την υγεία, από τον διαβήτη τύ...
Read More » -

Βγήκαν τα εργαστηριακά αποτελέσματα για γνωστό φάρμακο - Τι έδειξαν για την χρήση του;
Σημαντική εξέλιξη για το Zantac. Η υπηρεσία τροφίμων και φαρμάκων των ΗΠΑ (FDA) ανακοίνωσε τα αποτελέσματα από τους εργαστηριακούς ελέγχους.Σε προσομοίωση, η FDA διαπίστωσε ότι ΔΕΝ σχηματίζονται καρκι...
Read More » -

Χοληστερίνη: Ποια τα φυσιολογικά όρια; - Η σωστή αντιμετώπιση
Η ολική χοληστερίνη του αίματος, επίσης γνωστή ως το επίπεδο της χοληστερόλης ορού, αξιολογείται ανάλογα με τον κίνδυνο της καρδιαγγειακής ασθένειας που ο κάθε τύπος χοληστερόλης προκαλεί.Η χοληστερίν...
Read More » -

Πώς μαθαίνουμε να μην επιβραβεύουμε τον εαυτό μας με φαγητό;
Ήδη από μικρή ηλικία μαθαίνουμε να αντιμετωπίζουμε το φαγητό ως επιβράβευση. Φάγαμε όλο το μπρόκολο; Ορίστε μια σοκολάτα για επιβράβευση. Φέραμε καλούς βαθμούς στον έλεγχο; Πάμε έξω για φαγητό να το γ...
Read More » -

Λοίμωξη από σταφυλόκοκκο – Πώς θα την αναγνωρίσετε
Ο σταφυλόκοκκος μπορεί να εκδηλωθεί με μια ποικιλία συμπτωμάτων που κυμαίνονται από μικρά προβλήματα του δέρματος μέχρι και ενδοκαρδίτιδα, μια απειλητική για τη ζωή λοίμωξη του εσωτερικού τοιχώματος τ...
Read More » -

Βασίλης Κικίλιας: «Θέτουμε σε πλήρη λειτουργία 14 νέες κλίνες ΜΕΘ στο ΕΣΥ»
Στην «ομογενοποίηση» όλων των ενημερωτικών εκστρατειών που παίρνουν την έγκριση του υπουργείου Υγείας, προχωρά η κυβέρνηση.Στόχος του σχεδίου νόμου που θα έρθει το επόμενο διάστημα, είναι οι καμπάνιες...
Read More » -

Vegan έγινε φανατική κρεατοφάγος εξαιτίας ενός τσιμπήματος αράχνης
Τον Πίτερ Πάρκερ τον τσίμπησε αράχνη κι έγινε ο Spiderman, την Σίλβια Τέιμπορ την τσίμπησε αράχνη κι έγινε... κρεατοφάγος.Η Σίλβια Τέιμπορ είχε ορκιστεί πως δεν θα έτρωγε ποτέ ξανά κρέας, καθώς ήταν ...
Read More »
